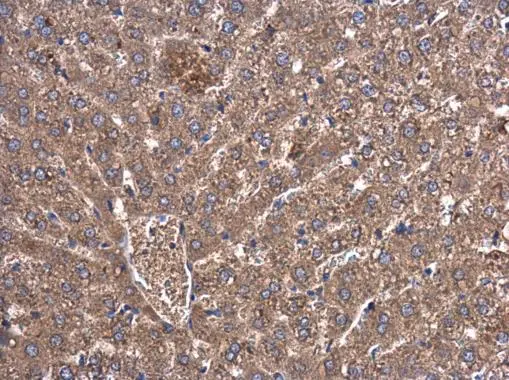
RBCK1 antibody detects RBCK1 protein at cytoplasm in rat liver by immunohistochemical analysis. Sample: Paraffin-embedded rat liver. RBCK1 antibody (GTX115451) diluted at 1:500. 
 Antigen Retrieval: Citrate buffer, pH 6.0, 15 min

RBCK1 antibody detects RBCK1 protein at cytosol on human breast carcinoma by immunohistochemical analysis. Sample: Paraffin-embedded human breast carcinoma. RBCK1 antibody (GTX115451) dilution: 1:500.
Antigen Retrieval: Trilogy? (EDTA based, pH 8.0) buffer, 15min
RBCK1 antibody
GTX115451
ApplicationsImmunoFluorescence, ImmunoCytoChemistry, ImmunoHistoChemistry, ImmunoHistoChemistry Paraffin
Product group Antibodies
ReactivityHuman, Mouse, Rat
TargetRBCK1
Overview
- SupplierGeneTex
- Product NameRBCK1 antibody
- Delivery Days Customer9
- Application Supplier NoteICC/IF: 1:100-1:1000. IHC-P: 1:100-1:1000. *Optimal dilutions/concentrations should be determined by the researcher.Not tested in other applications.
- ApplicationsImmunoFluorescence, ImmunoCytoChemistry, ImmunoHistoChemistry, ImmunoHistoChemistry Paraffin
- CertificationResearch Use Only
- ClonalityPolyclonal
- Concentration1 mg/ml
- ConjugateUnconjugated
- Gene ID10616
- Target nameRBCK1
- Target descriptionRANBP2-type and C3HC4-type zinc finger containing 1
- Target synonymsC20orf18, HOIL-1, HOIL1, PBMEI, PGBM1, RBCK2, RNF54, UBCE7IP3, XAP3, XAP4, ZRANB4, ranBP-type and C3HC4-type zinc finger-containing protein 1, HBV-associated factor 4, RBCC protein interacting with PKC1, RING finger protein 54, RING-type E3 ubiquitin transferase HOIL-1, heme-oxidized IRP2 ubiquitin ligase 1, hepatitis B virus X-associated protein 4, ubiquitin conjugating enzyme 7 interacting protein 3
- HostRabbit
- IsotypeIgG
- Protein IDQ9BYM8
- Protein NameRanBP-type and C3HC4-type zinc finger-containing protein 1
- Scientific DescriptionThe protein encoded by this gene is similar to mouse UIP28/UbcM4 interacting protein. Alternative splicing has been observed at this locus, resulting in distinct isoforms. [provided by RefSeq]
- ReactivityHuman, Mouse, Rat
- Storage Instruction-20°C or -80°C,2°C to 8°C
- UNSPSC12352203